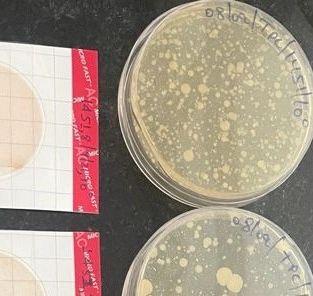

Rs. 2000 to learn HPLC in 5 days. Visit "PROGRAM" page for upcoming training program
Microbiology
Microbiology Basic

Preparation
- Safety guidelines
- Risk assessment
- Good microbiological laboratory practice (GMLP)
- Spillage management
- Aerosols

Resources
- Equipment
- Apparatus
- Materials

Media, sterilization and disinfectant
- Preparation of culture media
- Storage of media
- Sterilization vs. disinfection
- Use of the autoclave / pressure cooker
- Sterilization of equipment and materials
- Choice, preparation and use of disinfectants

Inoculation and other aseptic procedures
- Essential points
- Using a wire loop
- Using a pipette
- Flaming the neck of bottles and test tubes
- Streak plate
- pour plate
- Using a spreader
- Spread plate
- Membrane filtration
- MPN method

Incubation
We partner with industry leaders to ensure that our programmes meet the needs of the job market. Our industry partners provide us with feedback and guidance to keep our programmes relevant.
Copyright © 2025 FWAITH Training and Research Center - All Rights Reserved.
This website uses cookies.
We use cookies to analyze website traffic and optimize your website experience. By accepting our use of cookies, your data will be aggregated with all other user data.